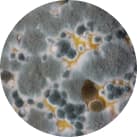
Sterilair: O que causa a rinite? Fungos.

Quais são os tipos de rinite?


Os dois tipos de rinite mencionados acima são as diferenciações mais básicas. Além destas, há também outros tipos com sintomas mais severos, como a rinite atrófica e a vasomotora, que têm sintomas bastante particulares e agressivos, os quais tornam ainda mais importante contar com acompanhamento médico e tratamentos adequados.
Rinite alérgica: o que é?
Segundo o Ministério da Saúde, a rinite alérgica é uma das doenças respiratórias crônicas mais comuns, representando um dos maiores problemas de saúde do mundo. Sua alta incidência pode ser justificada pelo fato de que o nariz é o meio de entrada para o ar, que, por sua vez, pode carregar substâncias que causam a irritação das mucosas nasais, como ácaros e esporos de mofo.
Em grande parte dos casos, a rinite alérgica está associada à asma. Desse modo, quem sofre de ambas as doenças pode ter sintomas mais severos, como dificuldade para respirar, dor no peito e respiração ofegante.
Sintomas da rinite

- Sintomas comuns
- Irritação no nariz, olhos ou garganta.
- Coceira e/ou prurido nos ouvidos e no nariz.
- Coriza.
- Secreção nasal transparente ou amarelada.
- Espirros.
- Lacrimejamento dos olhos.
- Outros sintomas
- Congestão nasal.
- Tosse.
- Diminuição da audição e do olfato.
- Dor de garganta.
- Olheiras e olhos inchados.
- Fadiga e irritabilidade.
- Cefaleia.
É importante ter em mente que a rinite, seja ela aguda ou crônica, alérgica ou não, pode acometer pessoas de qualquer idade.
Os sintomas sempre devem ser avaliados por um médico – especialmente, se os desconfortos forem persistentes, já que estes podem indicar casos mais graves, ou até mesmo uma rinite crônica.
O que causa a rinite?
Os diferentes tipos de rinite podem ter diversas causas. Abaixo, você confere as principais delas.

Vírus
Os vírus causadores dos resfriados comuns, geralmente, dão origem aos sintomas mais comuns de rinite, como coriza e espirros. Neste caso, o quadro deve melhorar em até dez dias, sem gerar impactos a médio/longo prazo para a qualidade de vida de quem foi infectado.

Ácaros
Ácaros – em especial, seus excrementos e ácaros mortos – têm um grande potencial alérgico. Quando ficam suspensos no ar, podem ser inalados juntamente de micropartículas de poeira ou outros contaminantes, sendo capazes de agravar ou causar uma crise de rinite alérgica

Fungos
Existem diversos tipos de fungos, mas os principais agentes alérgenos são os fungos chamados de “fungos anemófilos”. Presentes no ar, esses fungos circulam na atmosfera e são inalados com outras partículas, como poeira e gotículas, sendo muito reativos e capazes de causar complicações para quem possui asma, rinite ou ainda para quem tem tendência a desenvolvê-las.
Mofo
De forma simplificada, o mofo é um tipo de fungo que surge em ambientes úmidos e pouco ventilados. Por ser um microrganismo que também serve de alimento para os ácaros, ambos costumam aparecer juntos. Essa é uma combinação perigosa, que pode causar grandes alergias e contribuir para episódios de doenças respiratórias crônicas alérgicas.
Tratamento para rinite
Por enquanto, ainda não existe uma cura para a rinite. Porém há diversos tratamentos bastante eficazes, além de algumas atitudes que podem ser tomadas para aliviar os sintomas.
Os medicamentos a serem receitados podem variar conforme o tipo de rinite. Por isso, assim como com outras doenças respiratórias, recomendamos que você se consulte com um otorrinolaringologista para receber o tratamento adequado. Tenha em mente que a automedicação pode ser ineficaz, além de causar efeito rebote.
De modo geral, pacientes com rinite podem ser tratados com:
- Antibióticos
- Anti-histamínicos
- Cirurgias
- Soros nasais
- Injeções de dessensibilização
Cuidados necessários
Há alguns cuidados que você pode tomar em sua casa para prevenir ou aliviar os sintomas da rinite – em especial, a alérgica.
- 1Deixe as janelas abertas sempre que possível.
- 2Guarde objetos que favoreçam o aparecimento de ácaros, como bichos de pelúcia.
- 3Aspire/varra o chão e os móveis com frequência.
Diferença entre rinite e sinusite
Apesar de as duas doenças compartilharem alguns sintomas, rinite e sinusite acontecem em lugares diferentes do corpo: a primeira afeta as fossas nasais, enquanto a segunda, os seios da face. Além disso, a sinusite costuma ocasionar desconfortos bem mais intensos, mesmo em quadros mais moderados. Observar as secreções nasais também pode ser um bom jeito de diferenciar essas doenças, já que a secreção causada pela sinusite tende a ser mais espessa e amarelada que a que é causada pela maioria dos tipos de rinite.
De qualquer forma, tanto pessoas com rinite, quanto com sinusite, podem se beneficiar do uso de um purificador de ar.
Como Sterilair pode ajudar?

O Sterilair é um purificador de ar capaz de eliminar até 99,9% dos microrganismos suspensos no ar de um cômodo – dentre eles, vírus, fungos (mofo e bolor) e bactérias. Além disso, ele reduz significativamente a quantidade de ácaros.
Como uma das principais causas da rinite alérgica é a presença desses alérgenos no ar, o Sterilair pode ajudar a prevenir/diminuir os sintomas dessa e outras doenças respiratórias.
Sterilair ajuda a eliminar:
Vírus
Bactérias
Fungos
Ácaros
Veja como Sterilair já ajudou outras pessoas
Carregando avaliaçõesPerguntas Frequentes: rinite
Rinite atacada: o que fazer?
Caso você tenha rinite e não tenha recebido orientações de um otorrinolaringologista para lidar com as crises, recomendamos que você agende uma consulta. A automedicação e o uso de soros nasais sem orientação médica podem agravar o quadro a longo prazo. No entanto, caso a sua rinite seja alérgica, você pode tomar algumas medidas para aliviar os sintomas, como abrir as janelas e aspirar o pó do ambiente em que você está.
Rinite dá dor de cabeça?
A dor de cabeça não faz parte da lista de sintomas mais comuns da rinite, mas pode aparecer em alguns casos. Dependendo da pessoa, a rinite pode até mesmo favorecer crises de enxaqueca.
Rinite dá falta de ar?
Não, necessariamente. Porém, quando a rinite está associada a outras doenças respiratórias como asma, sinusite ou bronquite, é possível sentir falta de ar. Outro quadro que poderia causar falta de ar seria uma obstrução nasal como a que ocorre na rinite vasomotora.
Rinite dá febre?
A febre não está entre os sintomas que a rinite alérgica costuma causar. O surgimento desse sintoma, aliado à rinite, pode ser devido a um resfriado ou a quadros de saúde mais graves. De qualquer forma, apenas a avaliação médica poderá oferecer um diagnóstico preciso.
Rinite é doença crônica?
A rinite pode ser uma doença crônica, mas isso não é regra. Algumas pessoas podem experienciar sintomas da rinite temporariamente durante um resfriado e melhorar, sem grandes esforços.
Rinite emocional é possível?
Algumas pessoas com alergias podem apresentar pioras em momentos de estresse. Por isso, quem tem rinite alérgica pode presenciar uma piora dos sintomas durante momentos de instabilidade emocional.
Rinite ou sinusite: como diferenciar?
No geral, a sinusite causa dores e inchaço na face, especialmente nas áreas abaixo dos olhos e próximas ao nariz, algo que a rinite não costuma causar. As secreções nasais causadas por ambas também podem apresentar diferenças, já que, na rinite, a secreção costuma ser mais fluída e transparente, enquanto na sinusite ela tende a ser mais espessa e a apresentar coloração amarelada ou esverdeada.
Referências - Rinite:
Todas as informações sobre rinite abordadas nesta página tiveram como base estudos e dados divulgados por fontes relevantes e especializadas no assunto.
ABORL-CCF - Rinite Alérgica: Uma Inimiga Camuflada, 2003. Disponível em:https://www.aborlccf.org.br/secao_detalhes.asp?s=51&id=476
ACADEMIA BRASILEIRA DE RINOLOGIA - Dúvidas Sobre Rinite Alérgica, 2010. Disponível em:http://www.rinologia.org.br/duvidas-sobre-rinite-alergica/
MANUAL MSD - VERSÃO SAÚDE PARA A FAMÍLIA, Rinite - Distúrbios do Ouvido, Nariz e Garganta, 2020. Disponível em:https://www.msdmanuals.com/pt/casa/dist%C3%BArbios-do-ouvido,-nariz-e-garganta/doen%C3%A7as-do-nariz-e-dos-seios-paranasais/rinite
MINISTÉRIO DA SAÚDE, Cadernos de Atenção Básica: Doenças Respiratórias Crônicas, 2010. Disponível em:https://bvsms.saude.gov.br/bvs/publicacoes/doencas_respiratorias_cronicas.pdf
